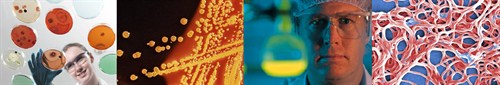
Bacteria (ecoli)

E. coli O157:H7 is spread by contact with infected fecal matter, which happens quite regularly. According to the Centers for Disease Control, everyone has some risk of infection from this bacterium

This bacterium has been responsible for numerous food recalls, illnesses and deaths. Exposure can cause severe stomach cramps, vomiting and kidney failure.
The data below demonstrates that copper actively kills E. coli O157:H7 while stainless steel and polyethylene, a common plastic, have virtually no effect after 360 minutes. As acknowledged by the U.S. EPA, Antimicrobial Copper kills more than 99.9% of E. coli O157:H7 within two hours.

Read more on the other bacteria that Antimicrobial Copper is registered to kill.
- MRSA : Methicillin-Resistant Staphylococcus aureus
- VRE : Vancomycin-Resistant Enterococcus faecalis
- Enterobacter aerogenes
- Pseudomonas aeruginosa